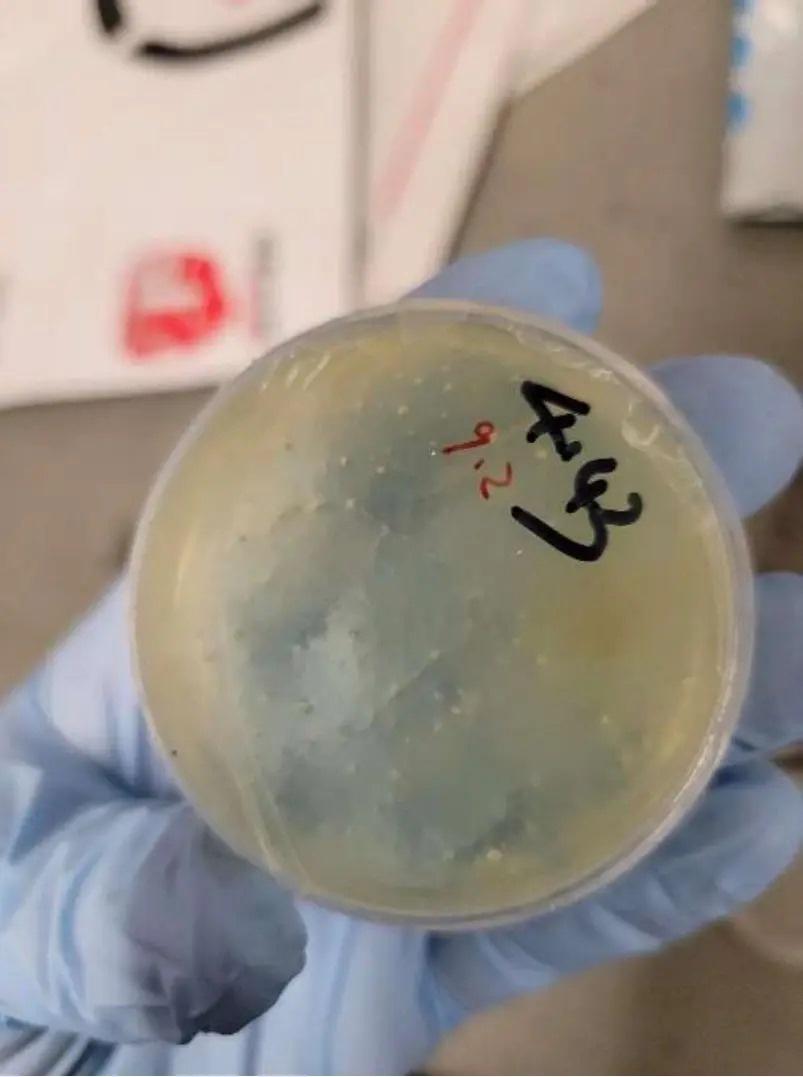
這名女科學家被指曾從中國向美國寄送4個包含生物材料的包裹。(X)

美國再拘中國科學家涉偷運生物材料,活體線蟲藏書夾層闖關。(網上截圖)
美國當局再控告一名中國科學家,涉嫌偷運生物材料進入美國。這是近日以來第2宗涉嫌走私生物材料的案件。美國聯邦當局當地時間8日拘捕一名來自中國武漢的中國籍科研人員Chengxuan Han(譯音:韓成萱),指其涉嫌走私與線蟲相關的生物材料入境美國,並在入境時向執法人員作出虛假陳述。
根據美國司法部公開資料,這名女科學家於2024至2025年間,曾從中國向美國寄送4個包含生物材料的包裹,收件人均為與密歇根大學實驗室有關人士。當局指出,女科學家所運送的樣本屬「未經申報、夾藏運輸、具敏感性質」的活體生物材料,她所攜生物材料是未申報的活體線蟲,藏於書本夾層內。女科學家於本月8日持交流人士的J1簽證抵達底特律大都會機場,當場被海關及邊境保護局人員截查。當時她否認曾寄送含有生物樣本的包裹,並謊稱自己並無涉及相關行為。然而調查人員發現,她曾在入境前3日刪除電子設備中的部分資料。在隨後由FBI與移民及海關執法局(ICE HIS)進行的深入問話中,Han承認包裹內容與線蟲相關,亦承認曾對海關人員作出虛假陳述。
中國駐芝加哥總領事館:反對美方藉意識形態與國安理由進行政治操弄
美國當局上周二亦指控另外兩名分別33和34歲的中國公民,包括譯音簡雲清的女子和譯音劉尊勇的男子,據報兩人為情侶。當局指,兩人涉嫌合謀,將「禾穀鐮刀菌」走私到美國,這種真菌被視為潛在農業恐怖主義武器,能破壞小麥、大麥、玉米和稻米等農作物,每年在全球造成幾十億美元經濟損失。
中國駐芝加哥總領事館對事件發表聲明,表示正通過相關渠道了解情況,並已就美方執法部門未履行《中美領事條約》義務提出嚴正交涉。中方強調,一貫要求國民遵守當地法律,並反對美方藉意識形態與國安理由進行政治操弄。